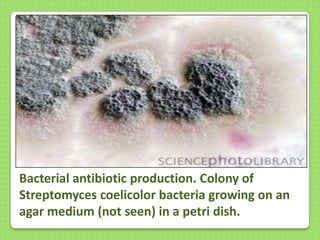
Bacterial antibiotic production. Colony of
Streptomyces coelicolor bacteria growing on an
agar medium (not seen) in a petri dish.

The document discusses two microorganisms: Methanospirillum hungatii, an anaerobic archaeon characterized by its spiral-shaped cells and ability to produce methane for fuel, and Streptomyces coelicolor, a gram-positive bacterium known for antibiotic production and environmental adaptability. Both are prokaryotic, unicellular, and play significant roles in ecological processes, with economic importance in waste treatment and nutrient cycling. They lack a nuclear membrane and do not perform photosynthesis.